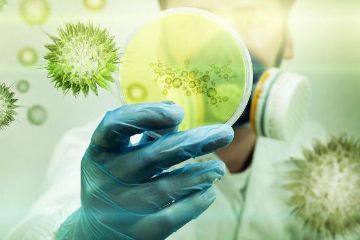

О нас
Почему нас выбирают
Если ваш дом заполонили надоедливые насекомые или участок осаждают вредители - мы избавим вас от этих проблем, чтобы ничего не омрачило спокойную жизнь и работу!
Уничтожаем неприятные запахи и плесень, обрабатываем помещения от вирусов и бактерий.

— Бесплатные Сайты и CRM.
— Бесплатные Сайты и CRM.